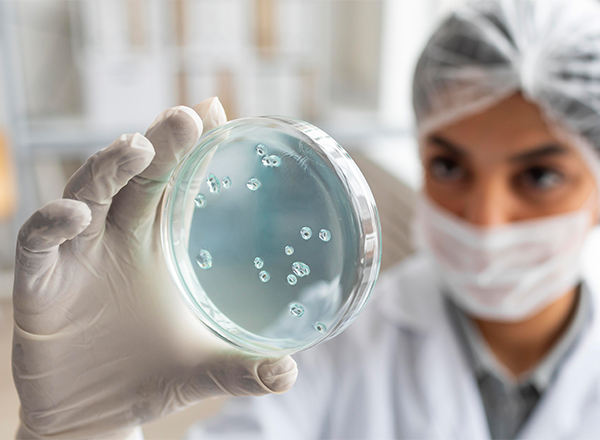
Farmacologia Clínica: Microbiologia, Imunologia e Quimioterapia

Certificado
Válido em todo o Brasil e alinhada às demandas do mercado.
APP exclusivo
Estude, acesse conteúdos, projetos e acompanhe sua evolução.
Cursos rápidos
Capacitações práticas de 30 horas para desenvolver suas habilidades
Certificado
Todos os cursos possuem certificados de conclusão.
APP exclusivo
Estude, acesse conteúdos, projetos e acompanhe sua evolução.
Cursos rápidos
Capacitações práticas e objetivas com aplicação no seu dia a dia.
Classificar Mais vendidos
-
Teoria Política e Serviço Social: Estado, Cidadania e Justiça -
Estatística Aplicada: Dados que Transformam Negócios -
Farmacologia Clínica: Microbiologia, Imunologia e Quimioterapia -
Missão em Ação: Planejamento e Estratégias para Evangelização Eficaz -
Algebra Linear para a Economia -
Coleta e Tratamento de Efluentes: Técnicas e Impactos Ambientais -
Projeto de Intervenção no Serviço Social: Método, Técnica e Ética -
Direito Aplicado Á Saúde -
Psicomotricidade e Aprendizagem Motora: Intervenções para Todas As Idades -
Gestão Esportiva na Prática: Planejamento, Eventos e Carreira em Educação Física -
Investimentos e Mercado de Capitais: Guia Prático para Investidores -
Fisioterapia Comunitária: Transformando Vidas e Fortalecendo Saúde -
Eletrônica Digital: da Lógica ao Projeto de Soluções Inovadoras -
Enfermagem em Alta Complexidade: Técnicas Avançadas, Farmacologia e Cuidado Humanizado -
Ensino de Inglês na Prática: Planejamento, Métodos e Habilidades para o Século 21 -
Atuação Cênica e Performativa: da História à Expressão Contemporânea -
Atuação do Engenheiro: Competências e Regulamentação Profissional -
Gestão Integrada de Saúde, Segurança e Sustentabilidade em Ambientes Hospitalares -
Psicomotricidade e Desenvolvimento Motor: da Teoria à Prática na Infância e Adolescência -
Educação em Saúde: Transformando Comunidades com Ações que Fazem a Diferença -
Demonstrações Contábeis na Prática: a Base para Decisões Empresariais -
Recrutamento & Seleção: Atraindo e Escolhendo Talentos -
Hemograma e Coagulograma na Prática Clínica -
Cultura Organizacional Estratégica: Clima, Poder e Desempenho
Perguntas Frequentes
Você pode se inscrever através do nosso site ou entrando em contato com nossa equipe.
Esta é a resposta para a pergunta frequente. Você pode usar formatação de texto, listas e links aqui.
Esta é a resposta para a pergunta frequente. Você pode usar formatação de texto, listas e links aqui.
Esta é a resposta para a pergunta frequente. Você pode usar formatação de texto, listas e links aqui.
Esta é a resposta para a pergunta frequente. Você pode usar formatação de texto, listas e links aqui.
Esta é a resposta para a pergunta frequente. Você pode usar formatação de texto, listas e links aqui.
Esta é a resposta para a pergunta frequente. Você pode usar formatação de texto, listas e links aqui.
A duração varia dependendo do curso escolhido. Consulte a página do produto para mais informações.
Sim, todos os nossos cursos são oferecidos online com suporte completo aos estudantes.
Sim, emitimos certificado para todos os cursos concluídos com sucesso.